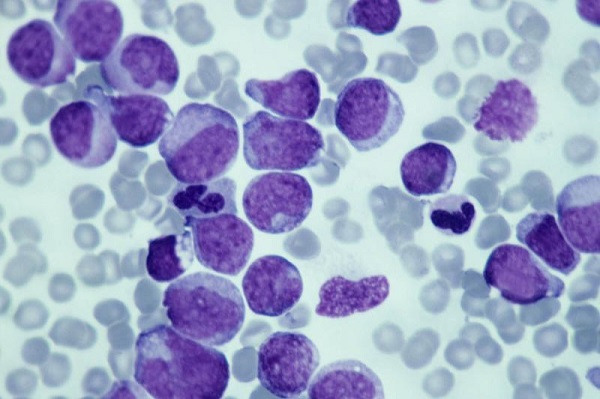

FDA批准Olutasidenib(Rezlidhia)用于IDH1突变的复发/难治性急性髓系白血病
美国食品和药物管理局(FDA)于12月1日批准olutasidenib(Rezlidhia)用于患有复发或难治性急性髓性白血病(AML)的成人患者,这些患者具有可通过雅培实时IDH1检测检测到的易感IDH1突变,该检测也获得了FDA的批准。
该批准基于研究2102-HEM-101的数据,这是一项开放标签,单臂,多中心1/2期试验。该研究招募了 147 名患有复发或难治性 AML 的成人,其 IHD1 突变已通过 Abbott 实时 IDH1 测定得到证实。
参与者每天两次接受150毫克口服胶囊的奥鲁他尼布,直到疾病进展,不可接受的毒性,或直到患者接受造血干细胞移植(HSCT)。中位治疗持续时间为4.7个月,范围为0.1至26个月。接受奥鲁他赛尼布治疗后,16例(11%)患者接受了HSCT。
在接受奥鲁他赛尼治疗的患者中,35%的患者表现出完全缓解(CR)或完全缓解伴部分血液学恢复(CRh)。其中包括CR的32%和CRh的2.7%。CR加CRh的中位时间为1.9个月,范围为0.9至5.6个月。CR加CRh的中位持续时间为25.9个月。
在基线时依赖红细胞(RBC)和/或血小板输注的86例患者中,34%在基线后任何56天内独立于血小板输注和红细胞。此外,在基线时独立于红细胞或血小板输注的61名患者中,64%的患者在基线后任何56天内都保持这种状态。
“CR + CRh的25.9个月中位持续时间对于AML患者来说是一个具有临床意义的改善,并且似乎比目前可用的治疗方案更长,”奥古斯塔佐治亚州癌症中心主任兼研究2102-HEM-101研究员Jorge E. Cortes医学博士在制药商Rigel Pharmaceuticals,Inc.的一份声明中说,“鉴于mIDH1 R / R AML成年患者的治疗选择有限, 通常预后不良的REZLIDHIA可能提供有效的,新的治疗选择,具有良好的安全性特征。
奥鲁他赛尼最常见的不良反应发生在20%或更多的患者中,是恶心,疲劳和不适,关节痛,便秘,白细胞增多,呼吸困难,发热,皮疹,粘膜炎,腹泻和转氨酶升高。FDA包括关于分化综合征风险的黑框警告。根据药物标签中的细节,接受奥鲁他西尼治疗的AML患者中有16%出现分化综合征,8%的患者发生3级或4级,1%的患者死亡。
Olutasidenib是一种口服药物,旨在结合和抑制突变的IDH1酶。该药物的推荐剂量为150毫克,应每天至少在饭前一小时或饭后两小时服用两次。根据FDA的说法,能够继续服用药物而没有不可接受的毒性或疾病进展的患者应该这样做,直到建议的六个月最短时间,这允许临床反应。
【温馨提示】
如需要更多Olutasidenib(Rezlidhia)资讯,欢迎与致泰药业联络查询。香港致泰药业是经香港政府卫生署注册的药品批发商,专注于全球新特药品进出口业务。

